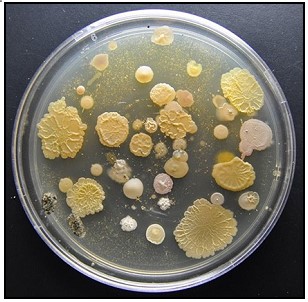
plate
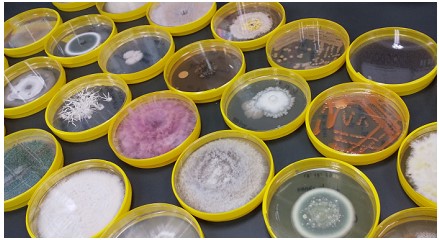
真菌プレート達

NBRCニュース 第85号

今号の内容
1.
新たにご利用可能となった微生物株
細菌では、カロテノイドの一種であるゼアキサンチンを産生するMuricauda属細菌(NBRC 115792, 115793)を公開しました。藻類では、建物の屋外コンクリートデッキの塗装表面から単離されたInterfilum sp. (class: Ulvophyceae) NBRC 113306を公開しました。また、細胞外多糖類(EPS)を産生するシアノバクテリア3株(NBRC 115796~115798)を公開しました。
【新たに提供を開始した微生物資源】
https://www.nite.go.jp/nbrc/cultures/nbrc/new_strain/new_dna.html
【新たに提供を開始した微生物資源】
https://www.nite.go.jp/nbrc/cultures/nbrc/new_strain/new_dna.html
2.
NBRC寄託株のご紹介(1)
紀州なれ寿司から分離したビフィズス菌
Bifidobacterium psychraerophilum Yasuke株と乳酸菌発酵茶に
必要なLactiplantibacillus plantarum kamigare株のご紹介
(岐阜大学応用生物科学部 岩橋 均)
この度、Bifidobacterium psychraerophilum Yasuke株(=NBRC 116469)とLactiplantibacillus plantarum kamigare株(=NBRC 116468)をNBRCに寄託しましたので、両株をご紹介させていただきます。
B. psychraerophilum Yasuke株は、「紀州なれ寿司」から分離されたビフィズス菌で、日本の伝統的発酵食品からビフィズス菌が分離されたのは初めてであると考えています。紀州なれ寿司は日本三大なれ寿司の一つといわれ、約800年以上の歴史があります。紀州なれ寿司は、サバを開き、1ヶ月以上塩漬けにした後、一晩水で塩を抜き、これを飯にのせ、ダンチクの葉で巻き、樽に詰めて重石をして発酵させます。発酵日数は1~2週間前後が一般的です。
我々は、明治時代を創業とし、なれ寿司を生産している和歌山市の「弥助寿司」から、製造の季節や発酵日数の異なる12本のなれ寿司を入手し、次世代シーケンサーを用いて菌叢解析を行いました。その結果、乳酸菌の発酵への貢献が確認されましたが、特定の属が優占となることはなく、発酵に関与する乳酸菌の多様性を確認しました(1)。その際、菌叢をよく観察すると、比較的発酵が進んだなれ寿司の菌叢にビフィズス菌の混在が観察されることがありました。
そこで、ビフィズス菌の分離を試みることにしました。先ず、ビフィズス菌が本当に存在することを確認するために、菌叢解析により混在が示唆された試料を用いて、ビフィズス菌を特異的に検出可能なプライマー(g-Bifid-Fとg-Bifid-R)を用いて特定の遺伝子の増幅を行い、比較的きれいな一本のバンドを得ました。これらの塩基配列を調べたところ、全ての試料の配列が同じであり、Bifidobacterium aquikeferi またはB. psychraerophilum であると推定されました。当研究室ではビフィズス菌を取り扱っていましたが分離の経験は無かったため、簡単に分離することはできませんでした。「弥助寿司」から、なれ寿司を何度か入手し、最終的には令和5年1月に入手した試料から分離することができました。分離したビフィズス菌は16S rRNAとhsp60遺伝子の相同性からB. psychraerophilumであると同定されました。また、次世代シーケンサーによるドラフトゲノム解析の結果からも同定が正しいことを確認し、本分離株をYasuke株と名付けました。
Yasuke株の耐酸性、耐酸素性、耐塩性をB. psychraerophilum、Bifidobacterium longum、 Bifidobacterium adolescentisそれぞれの基準株と比較したところ、Yasuke株は耐塩性と耐酸素性に優れていることが示唆されました。即ち、耐酸性は同程度であること、耐酸素性はB. psychraerophilum の基準株とは同程度だが他の2種よりは顕著に高いこと、耐塩性はB. psychraerophilum の基準株よりもやや高くまた他の2種と比べると明らかに高いことを確認しました。Yasuke株の起源については推測の域を出ませんが、「弥助寿司」に住み着いているのではと考えています。どの試料から遺伝子を取得しても同じ配列になり、耐塩性と耐酸素性もあることから、なれ寿司の生産環境に適していると考えられるからです。また、発酵の主役となる乳酸菌はサバを起源とすると推定され、多様性があるのに対し、ビフィズス菌には多様性がないからです。サバを起源とするのなら多様性があると考えられます。
ビフィズス菌といえば乳製品です。そこで、Yasuke株を用いてヨーグルトとチーズの作製に挑戦しました。市販の牛乳にYasuke株を添加し、市販のヨーグルトメーカを用いて発酵させたところ、牛乳が固化しpH4.0程度まで酸度が低下していました。当研究室に保存されているB. longum、B. adolescentis、Bifidobacterium lactisと比較しましたが、ここまで酸度を下げることのできるビフィズス菌はありませんでした。そのため、できあがったヨーグルトはかなり酸っぱく、これはYasuke株が酢酸を産生しているためと考えられます。チーズもヨーグルトメーカを用いてレンネットを添加することで作製を試みたところ、モッツァレラチーズ様のチーズができました。こちらはヨーグルトのような酸っぱさがなく、おいしいチーズになりました。ヨーグルトメーカで簡単にヨーグルトやチーズができたのは、Yasuke株が持つ耐酸素性に起因していると考えられ、扱いやすいビフィズス菌であると言えます。
Lactiplantibacillus plantarum kamigare株は、岐阜県の上ヶ流地区で後発酵茶を生産するために分離した乳酸菌です。後発酵茶とは、紅茶やウーロン茶のように酵素発酵させた茶ではなく、微生物発酵させた茶のことです。日本では、石鎚黒茶、阿波晩茶、碁石茶、バタバタ茶が知られています。玉露と同程度の価格で流通しており、付加価値の高いお茶として生産されています。石鎚黒茶と阿波晩茶の菌叢を解析したところ、Lactiplantibacillus属の乳酸菌が中心となって発酵していることが分かりました(2)。
一方で、岐阜県の上ヶ流地区には茶畑が広がっており、無農薬で生産されています。一番茶は出荷されますが、番茶は廃棄されるか乾燥番茶として安価に売られています。そこで、この乾燥番茶を上ヶ流地区から分離した乳酸菌を使って発酵させ、付加価値の高い後発酵茶を生産しようと考えました。上ヶ流地区の野草からLactiplantibacillus属の乳酸菌を分離し、その中から、後発酵茶に用いられる乳酸菌に特徴的な、殺菌ペプチドであるバクテリオシン遺伝子を持つ株を選択しました(3)。これが、上ヶ流地区のタンポポから分離されたL. plantarum kamigare株になります。kamigare株を用いると茶葉を嫌気条件にすることで後発酵茶を作ることが可能です。
【文献】
(1) Kubo et al. (2022). Biosci. Biotechnol. Biochem. 86 (12): 1705-1717
(2) Horie et al. (2023). Fermentation 9 (10): 876
(3) 刘 子路ら (2022). 美味技術学会誌 21 (1): 6-11
B. psychraerophilum Yasuke株は、「紀州なれ寿司」から分離されたビフィズス菌で、日本の伝統的発酵食品からビフィズス菌が分離されたのは初めてであると考えています。紀州なれ寿司は日本三大なれ寿司の一つといわれ、約800年以上の歴史があります。紀州なれ寿司は、サバを開き、1ヶ月以上塩漬けにした後、一晩水で塩を抜き、これを飯にのせ、ダンチクの葉で巻き、樽に詰めて重石をして発酵させます。発酵日数は1~2週間前後が一般的です。
我々は、明治時代を創業とし、なれ寿司を生産している和歌山市の「弥助寿司」から、製造の季節や発酵日数の異なる12本のなれ寿司を入手し、次世代シーケンサーを用いて菌叢解析を行いました。その結果、乳酸菌の発酵への貢献が確認されましたが、特定の属が優占となることはなく、発酵に関与する乳酸菌の多様性を確認しました(1)。その際、菌叢をよく観察すると、比較的発酵が進んだなれ寿司の菌叢にビフィズス菌の混在が観察されることがありました。
そこで、ビフィズス菌の分離を試みることにしました。先ず、ビフィズス菌が本当に存在することを確認するために、菌叢解析により混在が示唆された試料を用いて、ビフィズス菌を特異的に検出可能なプライマー(g-Bifid-Fとg-Bifid-R)を用いて特定の遺伝子の増幅を行い、比較的きれいな一本のバンドを得ました。これらの塩基配列を調べたところ、全ての試料の配列が同じであり、Bifidobacterium aquikeferi またはB. psychraerophilum であると推定されました。当研究室ではビフィズス菌を取り扱っていましたが分離の経験は無かったため、簡単に分離することはできませんでした。「弥助寿司」から、なれ寿司を何度か入手し、最終的には令和5年1月に入手した試料から分離することができました。分離したビフィズス菌は16S rRNAとhsp60遺伝子の相同性からB. psychraerophilumであると同定されました。また、次世代シーケンサーによるドラフトゲノム解析の結果からも同定が正しいことを確認し、本分離株をYasuke株と名付けました。
Yasuke株の耐酸性、耐酸素性、耐塩性をB. psychraerophilum、Bifidobacterium longum、 Bifidobacterium adolescentisそれぞれの基準株と比較したところ、Yasuke株は耐塩性と耐酸素性に優れていることが示唆されました。即ち、耐酸性は同程度であること、耐酸素性はB. psychraerophilum の基準株とは同程度だが他の2種よりは顕著に高いこと、耐塩性はB. psychraerophilum の基準株よりもやや高くまた他の2種と比べると明らかに高いことを確認しました。Yasuke株の起源については推測の域を出ませんが、「弥助寿司」に住み着いているのではと考えています。どの試料から遺伝子を取得しても同じ配列になり、耐塩性と耐酸素性もあることから、なれ寿司の生産環境に適していると考えられるからです。また、発酵の主役となる乳酸菌はサバを起源とすると推定され、多様性があるのに対し、ビフィズス菌には多様性がないからです。サバを起源とするのなら多様性があると考えられます。
ビフィズス菌といえば乳製品です。そこで、Yasuke株を用いてヨーグルトとチーズの作製に挑戦しました。市販の牛乳にYasuke株を添加し、市販のヨーグルトメーカを用いて発酵させたところ、牛乳が固化しpH4.0程度まで酸度が低下していました。当研究室に保存されているB. longum、B. adolescentis、Bifidobacterium lactisと比較しましたが、ここまで酸度を下げることのできるビフィズス菌はありませんでした。そのため、できあがったヨーグルトはかなり酸っぱく、これはYasuke株が酢酸を産生しているためと考えられます。チーズもヨーグルトメーカを用いてレンネットを添加することで作製を試みたところ、モッツァレラチーズ様のチーズができました。こちらはヨーグルトのような酸っぱさがなく、おいしいチーズになりました。ヨーグルトメーカで簡単にヨーグルトやチーズができたのは、Yasuke株が持つ耐酸素性に起因していると考えられ、扱いやすいビフィズス菌であると言えます。
Lactiplantibacillus plantarum kamigare株は、岐阜県の上ヶ流地区で後発酵茶を生産するために分離した乳酸菌です。後発酵茶とは、紅茶やウーロン茶のように酵素発酵させた茶ではなく、微生物発酵させた茶のことです。日本では、石鎚黒茶、阿波晩茶、碁石茶、バタバタ茶が知られています。玉露と同程度の価格で流通しており、付加価値の高いお茶として生産されています。石鎚黒茶と阿波晩茶の菌叢を解析したところ、Lactiplantibacillus属の乳酸菌が中心となって発酵していることが分かりました(2)。
一方で、岐阜県の上ヶ流地区には茶畑が広がっており、無農薬で生産されています。一番茶は出荷されますが、番茶は廃棄されるか乾燥番茶として安価に売られています。そこで、この乾燥番茶を上ヶ流地区から分離した乳酸菌を使って発酵させ、付加価値の高い後発酵茶を生産しようと考えました。上ヶ流地区の野草からLactiplantibacillus属の乳酸菌を分離し、その中から、後発酵茶に用いられる乳酸菌に特徴的な、殺菌ペプチドであるバクテリオシン遺伝子を持つ株を選択しました(3)。これが、上ヶ流地区のタンポポから分離されたL. plantarum kamigare株になります。kamigare株を用いると茶葉を嫌気条件にすることで後発酵茶を作ることが可能です。
【文献】
(1) Kubo et al. (2022). Biosci. Biotechnol. Biochem. 86 (12): 1705-1717
(2) Horie et al. (2023). Fermentation 9 (10): 876
(3) 刘 子路ら (2022). 美味技術学会誌 21 (1): 6-11
3.
DBRP掲載株のご紹介(7)
JAMSTEC深海微生物株ライブラリーのご紹介
(国立研究開発法人海洋研究開発機構生命理工学センター 布浦拓郎、澄田智美)
国立研究開発法人海洋研究開発機構(JAMSTEC)生命理工学センターでは、オープンイノベーションによる深海微生物からの新ビジネス創出を目指し、2020 年2 月より、深海バイオリソース(約1000種類の深海堆積物と約4500株の好気性深海微生物)を日本国内の民間企業・大学・研究機関に広く提供する、深海バイオリソース提供事業(https://www.jamstec.go.jp/cebn/bioresource/j/)を展開しています。この度、JAMSTEC深海微生物株ライブラリーの一部(バクテリア1267株と糸状菌・酵母58株)をNITEのDBRP(生物資源データプラットフォーム)に登録し、公開しました。

深海は、一般に、暗黒、低温、高圧の極限環境ですが、驚くべき生物多様性が維持されています。陸上微生物とは異なる固有の生存戦略を発達させた深海微生物は、希少生物資源であり、深海環境に適応する過程で獲得した多様な生存戦略をバイオテクノロジーに利活用することで、イノベーションを創出することが期待されています。
JAMSTECのこれまでの研究活動の中で収集された深海微生物コレクションは、好圧菌・好熱菌・嫌気微生物などの現場環境を再現する特殊な培養設備や技術が必要な微生物群と、通常の微生物取扱施設で容易に培養可能な好気性菌群に大別されます。JAMSTECでは、分類学上、あるいは学術的に貴重な微生物を国内外の微生物株保存機関に寄託して公開する一方、有用機能探索のスクリーニングライブラリーとして利用可能な大部分の深海微生物コレクションは非公開での保管を続けてきました。深海微生物の産業利用は世界的に見てもほとんど進んでおらず、その大きな理由として、多くの企業・研究機関にとって深海からのサンプルや微生物株の入手が極めて困難なことが挙げられます。そのため、陸上の微生物資源に比べて深海微生物からの機能探索の機会は大きく制限され、結果的にニーズの存在する場での利用・探索機会が限られてきました。そこで、オープンイノベーションによって深海微生物の有するポテンシャルを最大限に活用するため、JAMSTECでは独自に収集してきた有用機能探索用スクリーニングライブラリーを2020年2月に公開しました。深海バイオリソース提供事業では、日本領海・EEZ 内に由来する試料から単離され、ごく一般的な微生物取扱技術での継代・培養が可能であり、大気圧下好気条件において寒天平板培地でも容易に培養できる菌株群を提供しております。
JAMSTECのこれまでの研究活動の中で収集された深海微生物コレクションは、好圧菌・好熱菌・嫌気微生物などの現場環境を再現する特殊な培養設備や技術が必要な微生物群と、通常の微生物取扱施設で容易に培養可能な好気性菌群に大別されます。JAMSTECでは、分類学上、あるいは学術的に貴重な微生物を国内外の微生物株保存機関に寄託して公開する一方、有用機能探索のスクリーニングライブラリーとして利用可能な大部分の深海微生物コレクションは非公開での保管を続けてきました。深海微生物の産業利用は世界的に見てもほとんど進んでおらず、その大きな理由として、多くの企業・研究機関にとって深海からのサンプルや微生物株の入手が極めて困難なことが挙げられます。そのため、陸上の微生物資源に比べて深海微生物からの機能探索の機会は大きく制限され、結果的にニーズの存在する場での利用・探索機会が限られてきました。そこで、オープンイノベーションによって深海微生物の有するポテンシャルを最大限に活用するため、JAMSTECでは独自に収集してきた有用機能探索用スクリーニングライブラリーを2020年2月に公開しました。深海バイオリソース提供事業では、日本領海・EEZ 内に由来する試料から単離され、ごく一般的な微生物取扱技術での継代・培養が可能であり、大気圧下好気条件において寒天平板培地でも容易に培養できる菌株群を提供しております。 バイオリソース提供事業において提供される深海微生物ライブラリーは、有人潜水調査船の「しんかい2000」や「しんかい6500」、あるいは初代「かいこう」などの無人探索機を用いて、日本近海(相模湾・駿河湾・南海トラフ・沖縄トラフ・琉球海溝・日本海溝・伊豆小笠原海溝など)から採取された微生物株からなります。その中には、通常の深海堆積物由来の株の他、鯨骨生物群集や地球深部掘削船「ちきゅう」による海底下堆積物に由来する株も含まれます。
バイオリソース提供事業において提供される深海微生物ライブラリーは、有人潜水調査船の「しんかい2000」や「しんかい6500」、あるいは初代「かいこう」などの無人探索機を用いて、日本近海(相模湾・駿河湾・南海トラフ・沖縄トラフ・琉球海溝・日本海溝・伊豆小笠原海溝など)から採取された微生物株からなります。その中には、通常の深海堆積物由来の株の他、鯨骨生物群集や地球深部掘削船「ちきゅう」による海底下堆積物に由来する株も含まれます。 現在のJAMSTECの深海微生物コレクションは今回DBRPに掲載した株を含め、いずれも好気性の約6000株以上のバクテリア株と、約1000株以上の糸状菌・酵母株からなり、液体窒素保存容器内で凍結保存されています。バクテリア株は、Marine Agar 2216など市販の海洋微生物培養培地での培養と維持が可能です。また、その生育温度は4℃から中温域の30℃程度です。利用に際して、「深海微生物は低温や高圧での培養が必要でしょうか?」とのご質問を受けますが、実際には常圧で培養できる株も極めて多く、また、最も多くの株を得ることができる培養温度も、深海の現場温度より高い15~20℃程度です。糸状菌・酵母株の大部分は、20~25℃の至適培養温度を示すものからなります。また、高濃度塩分耐性を示す糸状菌・酵母株は多いですが、塩分要求性を示す株はほとんどいません。これらの深海微生物コレクションは、日本周辺のさまざまな海域の深海環境に由来します。具体的には相模湾、駿河湾の他、鹿児島湾、南海トラフ、沖縄トラフ、南西諸島沖、仙台沖、そして伊豆・小笠原海溝や日本海溝といった水深6000 mを超える超深海域などになります。
現在のJAMSTECの深海微生物コレクションは今回DBRPに掲載した株を含め、いずれも好気性の約6000株以上のバクテリア株と、約1000株以上の糸状菌・酵母株からなり、液体窒素保存容器内で凍結保存されています。バクテリア株は、Marine Agar 2216など市販の海洋微生物培養培地での培養と維持が可能です。また、その生育温度は4℃から中温域の30℃程度です。利用に際して、「深海微生物は低温や高圧での培養が必要でしょうか?」とのご質問を受けますが、実際には常圧で培養できる株も極めて多く、また、最も多くの株を得ることができる培養温度も、深海の現場温度より高い15~20℃程度です。糸状菌・酵母株の大部分は、20~25℃の至適培養温度を示すものからなります。また、高濃度塩分耐性を示す糸状菌・酵母株は多いですが、塩分要求性を示す株はほとんどいません。これらの深海微生物コレクションは、日本周辺のさまざまな海域の深海環境に由来します。具体的には相模湾、駿河湾の他、鹿児島湾、南海トラフ、沖縄トラフ、南西諸島沖、仙台沖、そして伊豆・小笠原海溝や日本海溝といった水深6000 mを超える超深海域などになります。 これまでの本事業利用者による深海バイオリソースの利用は、深海微生物に固有の機能を探索するよりも、既存の陸上微生物を対象にしたスクリーニング系に深海微生物株を組み込む利用法が多く、主に新規酵素や新規生理活性物質の探索に利用されています。最も実用化に近い事例として、ケイ・アイ化成(株)とビタミンC60バイオリサーチ(株)により、海洋酵母が生成する新規カロテノイド(明治大学浜本教授らが発見)の機能性化粧品原料としての実用化に向けた取り組みが進められています。
これまでの本事業利用者による深海バイオリソースの利用は、深海微生物に固有の機能を探索するよりも、既存の陸上微生物を対象にしたスクリーニング系に深海微生物株を組み込む利用法が多く、主に新規酵素や新規生理活性物質の探索に利用されています。最も実用化に近い事例として、ケイ・アイ化成(株)とビタミンC60バイオリサーチ(株)により、海洋酵母が生成する新規カロテノイド(明治大学浜本教授らが発見)の機能性化粧品原料としての実用化に向けた取り組みが進められています。【JAMSTEC株コレクション情報】
https://www.nite.go.jp/nbrc/dbrp/dataview?dataId=COLL0000900000001
https://www.nite.go.jp/nbrc/dbrp/dataview?dataId=COLL0000900000001
4.
手数料改定のお知らせ
NBRCでは、「独立行政法人の事務・事業の見直しの基本方針(平成22年12月7日閣議決定)※」に基づき受益と負担の適正化を考慮し、実費を勘案した手数料を利用者の皆様にご負担いただいております。この度、直近の実費に基づき見直しを行い、2024年4月1日から手数料を改定させていただくことになりましたのでお知らせいたします。
新しい手数料額の詳細は、こちらをご確認ください。今後もサービスの継続とさらなる品質向上に努めてまいりますので、何卒ご理解を賜りますようお願い申し上げます。
【2024年4月1日から手数料を改定する業務(証明書の発行等関連する業務を含みます)】
・NBRC株の分譲
・RD株の提供
・DNAリソースの分譲
・生物遺伝資源バックアップサービス
・NBRC微生物カクテルの提供
・継続保管
【手数料改定のお知らせ】 https://www.nite.go.jp/nbrc/cultures/information/amendment_of_fee_FY2023.html
※「独立行政法人の事務・事業の見直しの基本方針(平成22年12月7日閣議決定)」において、「特定の者が検査料、授業料、利用料、配布価格、技術指導料等を負担して実施する事業については、受益者の負担を適正なものとする観点から、その負担の考え方を整理し、これに基づき、国民生活への影響に配慮しつつ検査料等の見直しを行う。」とされております。
新しい手数料額の詳細は、こちらをご確認ください。今後もサービスの継続とさらなる品質向上に努めてまいりますので、何卒ご理解を賜りますようお願い申し上げます。
【2024年4月1日から手数料を改定する業務(証明書の発行等関連する業務を含みます)】
・NBRC株の分譲
・RD株の提供
・DNAリソースの分譲
・生物遺伝資源バックアップサービス
・NBRC微生物カクテルの提供
・継続保管
【手数料改定のお知らせ】 https://www.nite.go.jp/nbrc/cultures/information/amendment_of_fee_FY2023.html
※「独立行政法人の事務・事業の見直しの基本方針(平成22年12月7日閣議決定)」において、「特定の者が検査料、授業料、利用料、配布価格、技術指導料等を負担して実施する事業については、受益者の負担を適正なものとする観点から、その負担の考え方を整理し、これに基づき、国民生活への影響に配慮しつつ検査料等の見直しを行う。」とされております。
5.
NBRCが展示、発表等を行うイベントについて
特定非営利活動法人 国際生命科学研究機構(ILSI Japan)食品微生物研究部会との共催で以下のシンポジウムを開催し、講演等を行います。ぜひご参加ください。
ILSI Japan・NITE合同公開シンポジウム2024
~食品産業において求められる微生物検査と法令対応~
日時:2024年3月8日(金) 13:10~17:35
形式:対面形式(※オンライン無し)
共催:特定非営利活動法人国際生命科学研究機構(ILSI Japan)食品微生物研究部会
独立行政法人製品評価技術基盤機構(NITE)
会場:三菱ケミカル株式会社 Science & Innovation Center 大ホール
(神奈川県横浜市青葉区鴨志田町1000番地)
定員:150名(先着)
申込方法:事前参加登録(有料・事前申込のみ)
下記URLから事前に参加登録を行ってください。
https://app.payvent.net/embedded_forms/show/65a76f8b240b2426dcb7fb06
申込期間:2024年1月26日(金)~2024年2月27日(火)
詳細:https://www.nite.go.jp/nbrc/kouhou/NITE_ILSI_symposium.html (NITE Website)
https://ilsijapan-org.prm-ssl.jp/ILSIJapan/LEC/SM2024/SM2024.php(ILSI Website)
案内チラシ:
https://ilsijapan-org.prm-ssl.jp/ILSIJapan/LEC/SM2024/ILSI%20Japan%20symposium_20240308.pdf
また、以下のイベントにて講演、発表等を行います。ぜひご参加ください。
第58回日本水環境学会年会
日時:2024年3月6日(水)~8日(金)
会場:九州大学伊都キャンパス(福岡県福岡市西区元岡744)
URL:https://www.jswe.or.jp/event/lectures/index.html
NITEの参加形態:ポスター発表
公益財団法人発酵研究所 学会・研究部会助成 公開シンポジウム
「微生物リソース整備とその利活用:現状と今後の展望」
日時:2024年3月12日(火)10:00~17:20
会場:東京国際フォーラムホール D5(東京都千代田区丸の内3-5-1)
URL:https://www.jsmrs.jp/ja/#jsmrs_sympo2024open
NITEの参加形態:講演
日本農芸化学会2024年度東京大会 創立100周年記念大会
日時:2024年3月24日(日)~27日(水)
会場:東京農業大学 世田谷キャンパス (東京都世田谷区桜丘1-1-1)
URL:https://www.jsbba.or.jp/2024/
NITEの参加形態:シンポジウム等での講演(2S07A3p、3S15A3p、4C5a06)
以下は、NBRCがバイオものづくりで連携している近畿経済産業局が主催するイベントです。ぜひご参加ください。
関西バイオものづくりフォーラム2024
日時:2024年3月8日(金) 13:00-18:30
会場:中之島センタービル2階 NCB会館 松の間
(大阪府大阪市北区中之島6-2-27)及びオンライン
URL:
https://www.kansai.meti.go.jp/2-4bio/biomonodukuri/biomonodukuri_forum2024.html
ILSI Japan・NITE合同公開シンポジウム2024
~食品産業において求められる微生物検査と法令対応~
日時:2024年3月8日(金) 13:10~17:35
形式:対面形式(※オンライン無し)
共催:特定非営利活動法人国際生命科学研究機構(ILSI Japan)食品微生物研究部会
独立行政法人製品評価技術基盤機構(NITE)
会場:三菱ケミカル株式会社 Science & Innovation Center 大ホール
(神奈川県横浜市青葉区鴨志田町1000番地)
定員:150名(先着)
申込方法:事前参加登録(有料・事前申込のみ)
下記URLから事前に参加登録を行ってください。
https://app.payvent.net/embedded_forms/show/65a76f8b240b2426dcb7fb06
申込期間:2024年1月26日(金)~2024年2月27日(火)
詳細:https://www.nite.go.jp/nbrc/kouhou/NITE_ILSI_symposium.html (NITE Website)
https://ilsijapan-org.prm-ssl.jp/ILSIJapan/LEC/SM2024/SM2024.php(ILSI Website)
案内チラシ:
https://ilsijapan-org.prm-ssl.jp/ILSIJapan/LEC/SM2024/ILSI%20Japan%20symposium_20240308.pdf
また、以下のイベントにて講演、発表等を行います。ぜひご参加ください。
第58回日本水環境学会年会
日時:2024年3月6日(水)~8日(金)
会場:九州大学伊都キャンパス(福岡県福岡市西区元岡744)
URL:https://www.jswe.or.jp/event/lectures/index.html
NITEの参加形態:ポスター発表
公益財団法人発酵研究所 学会・研究部会助成 公開シンポジウム
「微生物リソース整備とその利活用:現状と今後の展望」
日時:2024年3月12日(火)10:00~17:20
会場:東京国際フォーラムホール D5(東京都千代田区丸の内3-5-1)
URL:https://www.jsmrs.jp/ja/#jsmrs_sympo2024open
NITEの参加形態:講演
日本農芸化学会2024年度東京大会 創立100周年記念大会
日時:2024年3月24日(日)~27日(水)
会場:東京農業大学 世田谷キャンパス (東京都世田谷区桜丘1-1-1)
URL:https://www.jsbba.or.jp/2024/
NITEの参加形態:シンポジウム等での講演(2S07A3p、3S15A3p、4C5a06)
以下は、NBRCがバイオものづくりで連携している近畿経済産業局が主催するイベントです。ぜひご参加ください。
関西バイオものづくりフォーラム2024
日時:2024年3月8日(金) 13:00-18:30
会場:中之島センタービル2階 NCB会館 松の間
(大阪府大阪市北区中之島6-2-27)及びオンライン
URL:
https://www.kansai.meti.go.jp/2-4bio/biomonodukuri/biomonodukuri_forum2024.html
編集後記
今号でご紹介したYasuke株を使ったチーズやkamigare株を使った後発酵茶、おいしそうです!菌叢解析や微生物研究の進展によって、分離株の新しい使い道が広がっていくのは素敵ですね。(YU)
今号でご紹介したYasuke株を使ったチーズやkamigare株を使った後発酵茶、おいしそうです!菌叢解析や微生物研究の進展によって、分離株の新しい使い道が広がっていくのは素敵ですね。(YU)
・画像付きのバックナンバーを以下のサイトに掲載しております。受信アドレス変更、受信停止も以下のサイトからお手続きいただけます。
NBRCニュースバックナンバー
・NBRCニュースは配信登録いただいたメールアドレスにお送りしております。万が一間違えて配信されておりましたら、お手数ですが、以下のアドレスにご連絡ください。
・ご質問、転載のご要望など、NBRCニュースについてのお問い合わせは、以下のアドレスにご連絡ください。
・掲載内容を許可なく複製・転載することを禁止します。
・NBRCニュースは偶数月の1日(休日の場合はその前後)に配信します。次号(第85号)は2024年3月22日に配信予定です。
編集・発行
独立行政法人製品評価技術基盤機構(NITE)バイオテクノロジーセンター(NBRC)
NBRCニュース編集局(nbrcnews【@】nite.go.jp)
(メールを送信される際は@前後の【】を取ってご利用ください)
NBRCニュースバックナンバー
・NBRCニュースは配信登録いただいたメールアドレスにお送りしております。万が一間違えて配信されておりましたら、お手数ですが、以下のアドレスにご連絡ください。
・ご質問、転載のご要望など、NBRCニュースについてのお問い合わせは、以下のアドレスにご連絡ください。
・掲載内容を許可なく複製・転載することを禁止します。
・NBRCニュースは偶数月の1日(休日の場合はその前後)に配信します。次号(第85号)は2024年3月22日に配信予定です。
編集・発行
独立行政法人製品評価技術基盤機構(NITE)バイオテクノロジーセンター(NBRC)
NBRCニュース編集局(nbrcnews【@】nite.go.jp)
(メールを送信される際は@前後の【】を取ってご利用ください)
お問い合わせ
-
独立行政法人製品評価技術基盤機構 バイオテクノロジーセンター
生物資源利用促進課
(お問い合わせはできる限りお問い合わせフォームにてお願いします) -
TEL:0438-20-5763
住所:〒292-0818 千葉県木更津市かずさ鎌足2-5-8 地図
お問い合わせフォームへ














